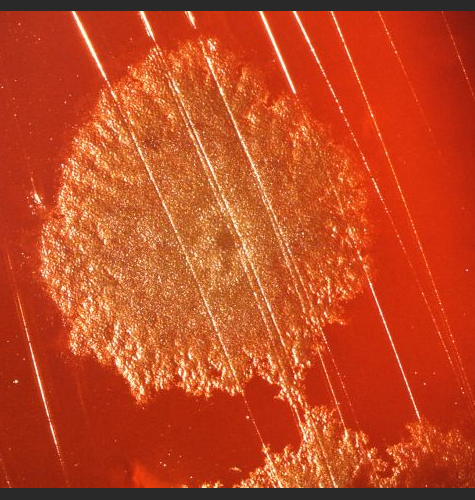
Clostridium Bacteria

1. What is a biological weapon?
- A biological weapon is a system that disseminates microorganisms or toxins to sicken or kill people, animals, or plants. It generally consists of two parts:
- A weaponized causative agent
- A delivery system
- The causative agent can be microorganisms that causes disease, such as bacteria, viruses, or fungi, or chemicals derived from living organisms such as prions and toxins.
- Delivery systems range from very simple devices (e.g., an envelope, brushes, basic injection systems, or food and water contamination) to sophisticated devices (e.g., aerosol spray devices, bombs, and missiles).
2. Have biological weapons ever been used?
3. Which countries have or at one time had biological weapons?
4. What is the difference between offensive biological weapons programs and biodefense?
The Biological and Toxins Weapons Convention (BTWC) prohibits its members from undertaking offensive biological weapons activities but permits research and the development of antidotes and other defenses against biological weapons. It can be difficult to delineate the boundary between offensive and defensive programs because offensive and defensive research often employ the same equipment, technologies and techniques. The following scenarios illustrate the difficulty of categorizing biological programs as offensive or defensive.
Scenario 1: Scientists genetically engineer a new and deadly strain of a common BW agent. |
|
| Why it could be biological warfare: Past BW programs have tried to re-engineer existing pathogens to leave their adversaries without the usual defenses against them. |
Why it could be biodefense: A scientist working on antiviral drug development might be trying to understand how, and how fast, the virus could evolve to resist treatment. |
Scenario 2: A disease outbreak occurs near a military base known to work with biological agents. |
|
| Why it could be biological warfare: Leaks from biological weapons research and production can lead to disastrous outbreaks. Notably, the 1979 anthrax leak in Sverdlovsk, USSR resulted in approximately 100 deaths. |
Why it could be biodefense: Defensive biological programs also use agents which could lead to an outbreak if mishandled. Additionally, some BW agents like Bacillus anthracis exist in nature and outbreaks may have natural causes. |
Scenario 3: Military units conduct tests of aerosol dispersal agents at a remote, outdoor test facility. |
|
| Why it could be biological warfare: A country planning a large-scale biological attack would need to test aerosol technologies to successfully disperse biological warfare agents. |
Why it could be biodefense: Aerosol tests are necessary for biological defense, to test aerosol detection systems and to train troops on the use of biological disinfectants. |
Scenario 4: The military initiates a campaign to inoculate its troops against anthrax. |
|
| Why it could be biological warfare: The military may be trying to ensure that its forces are protected from blowback of agents that it may use on the battlefield. |
Why it could be biodefense: The military may just be trying to ensure that its forces are prepared for anything that the enemy may use against them. |
Scenario 5: Military medical personnel seek to obtain deadly viral strains from abroad. |
|
| Why it could be biological warfare: A state seeking to develop a biological weapons program may attempt to procure biological agents elsewhere, particularly if it lacks an advanced biomedical industry. |
Why it could be biodefense: The military may be participating in public health or biodefense initiatives with the help of a foreign entity. |
Photo Credit
Header Image: Electron micrograph of Escherichia coli. Source: WikiMedia Commons.